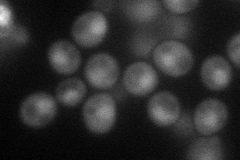
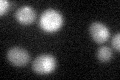
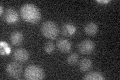

View description
Regulatory subunit of the Glc7p type-1 protein phosphatase; involved with Reg1p, Glc7p, and Snf1p in regulation of glucose-repressible genes, also involved in glucose-induced proteolysis of maltose permease
Localization:
Intensity:
Fold change:
Significance:
-
C’ GFP library in SD

below threshold17.07 -
N' NOP1pr-GFP in SD
nucleus56.0129 -
N' TEF2pr-mCherry in SD

nucleus8.05318 -
N' NATIVEpr-GFP in SD

below threshold18.5297 -
N' TEF2pr-VC and Cyto-VN in SD

below threshold22.6778 -
C’ GFP library in SD+DTT
cytosol17.11No -
C’ GFP library in SD+H2O2

cytosol17.731.03No -
C’ GFP library in Starvation Media
cytosol16.30.95No -
C’ GFP library on the background of Pup2-DaMP

below threshold -
C’ GFP library on the background of CCT mutant

below threshold17.1661.00492No
